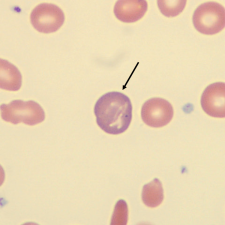
<p>What is the color of this erythrocyte?</p>
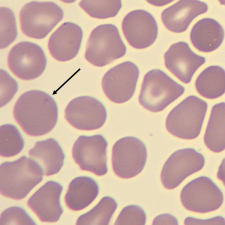
<p>What characteristic describes this erythrocyte?</p>
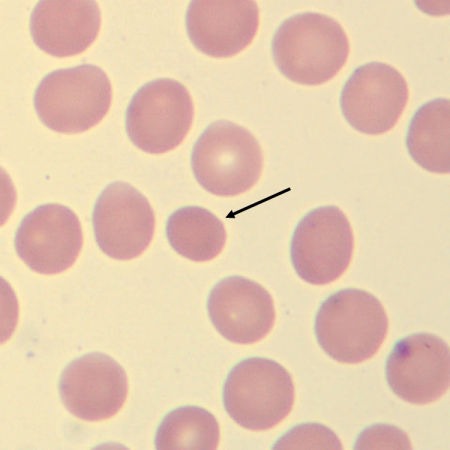
<p>What characteristic describes this erythrocyte?</p>
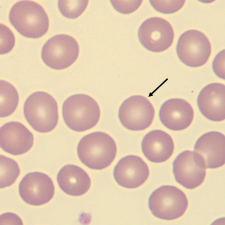
<p>What characteristic describes the size of this erythrocyte?</p>
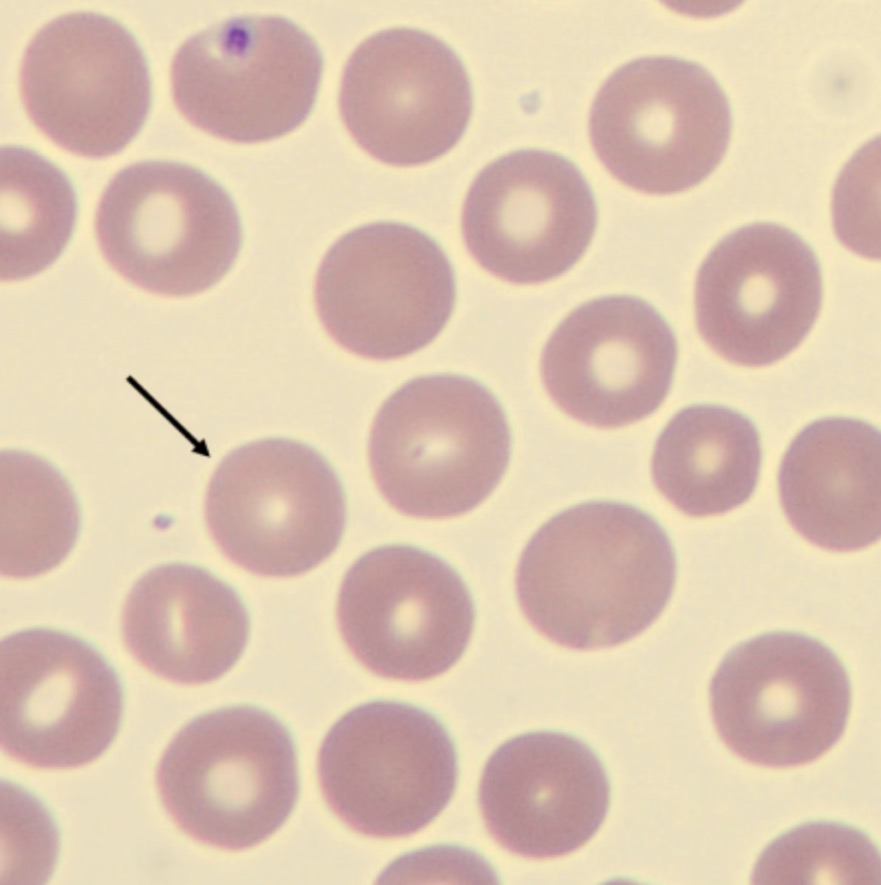
<p>What characteristic describes the size of this erythrocyte?</p>
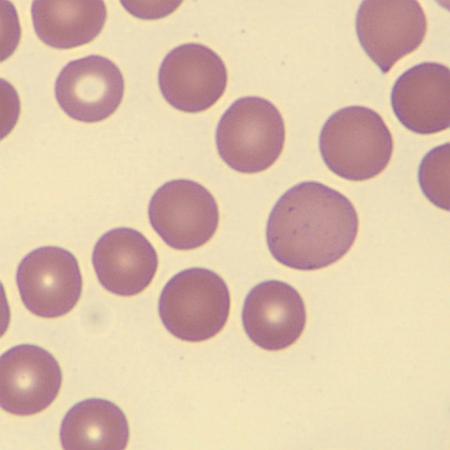
<p>What do these erythrocytes show?</p>
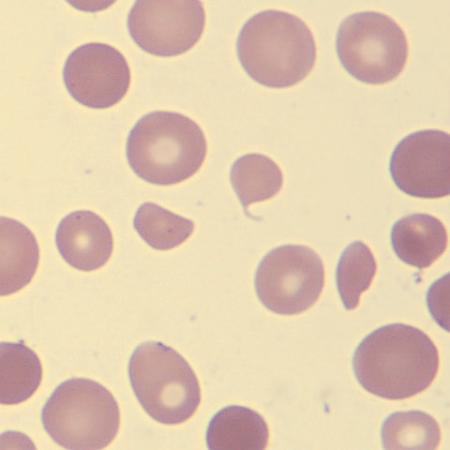
<p>What do these erythrocytes show?</p>
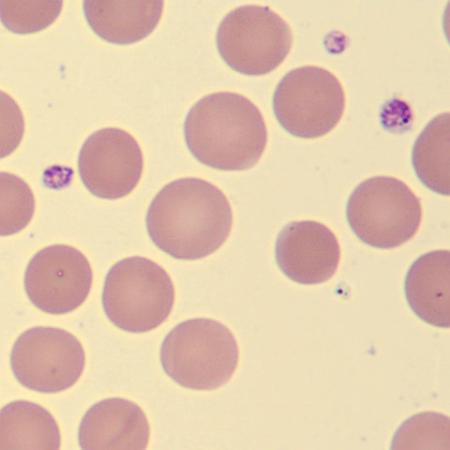
<p>What do these erythrocytes show?</p>
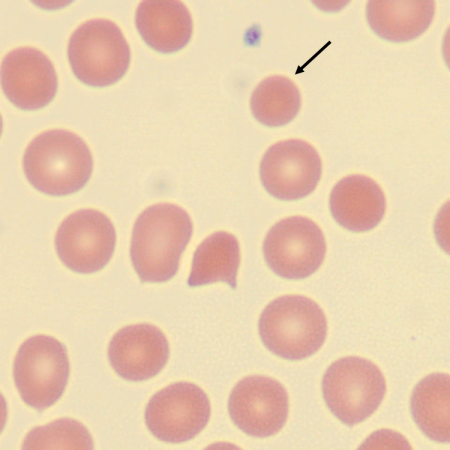
<p>What characteristic describes the size of this erythrocyte?</p>
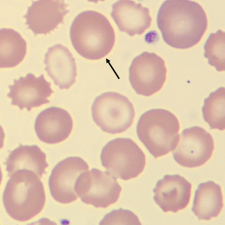
<p>What characteristic describes the size of this erythrocyte?</p>
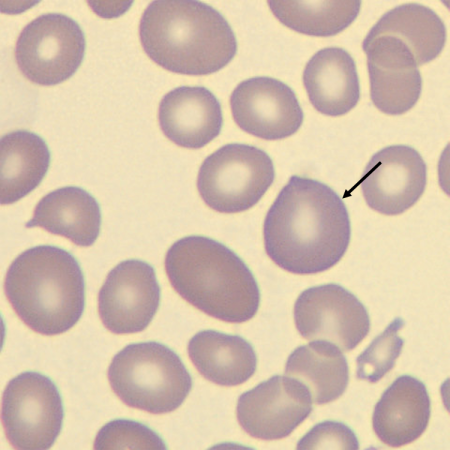
<p>What characteristic describes the size of this erythrocyte?</p>
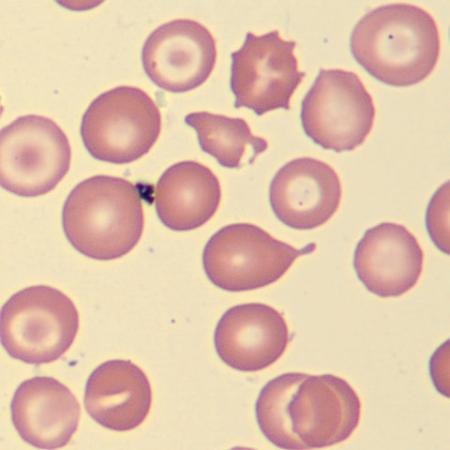
<p>What do these erythrocytes show?</p>
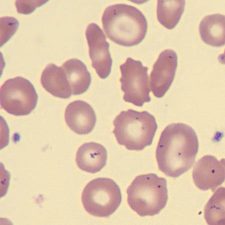
<p>What do these erythrocytes show?</p>
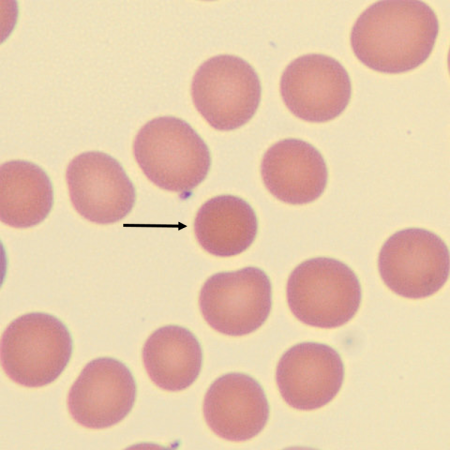
<p>What is the shape of this erythrocyte?</p>
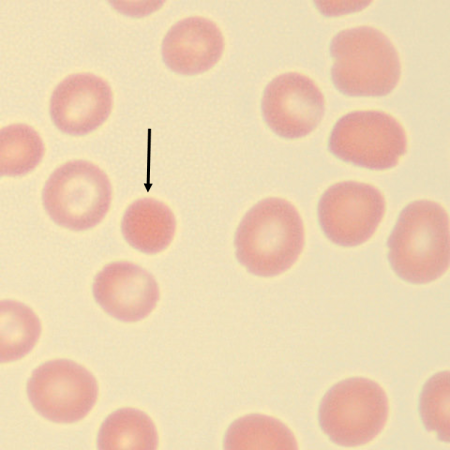
<p>What is the shape of this erythrocyte?</p>
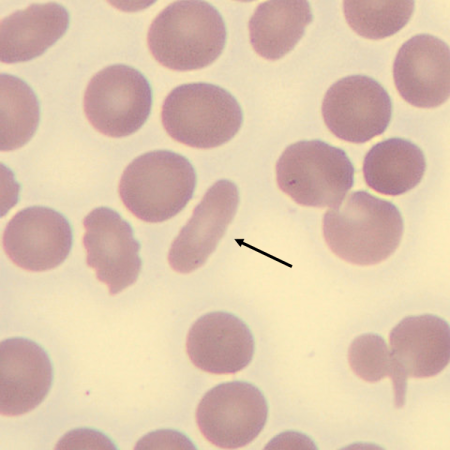
<p>What is the shape of this erythrocyte?</p>
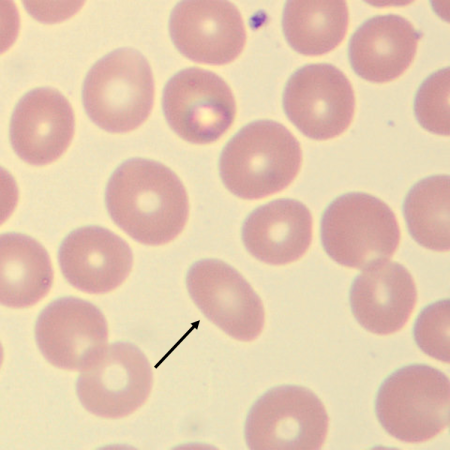
<p>What is the shape of this erythrocyte?</p>
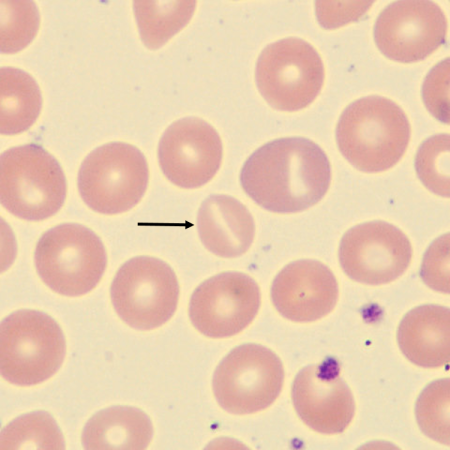
<p>What is the shape of this erythrocyte?</p>
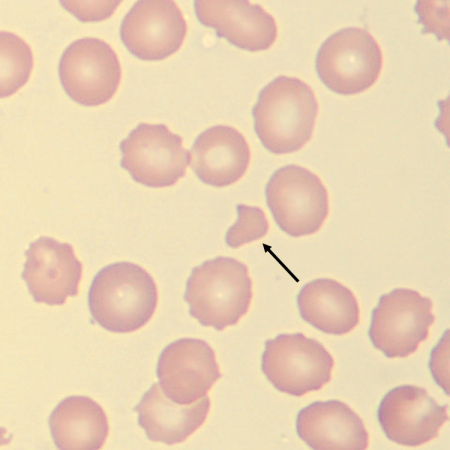
<p>What is the shape of this erythrocyte?</p>
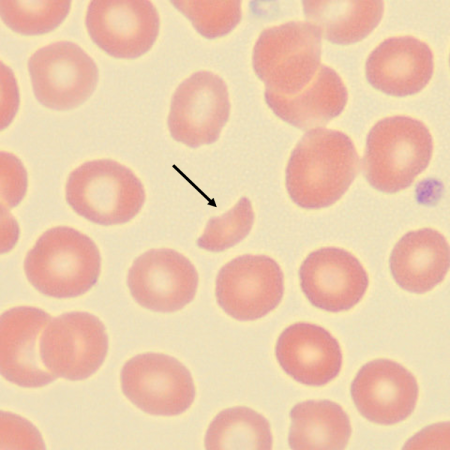
<p>What is the shape of this erythrocyte?</p>
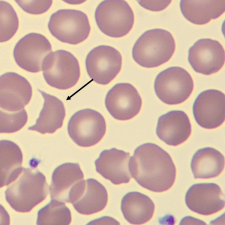
<p>What is the shape of this erythrocyte?</p>
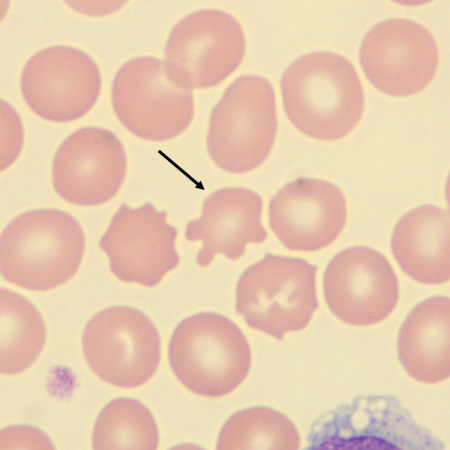
<p>What is the shape of this erythrocyte?</p>
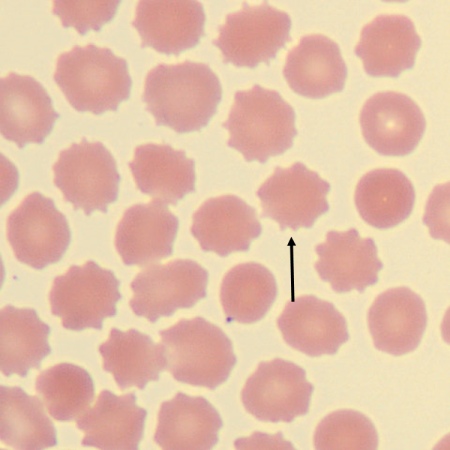
<p>What is the shape of this erythrocyte?</p>
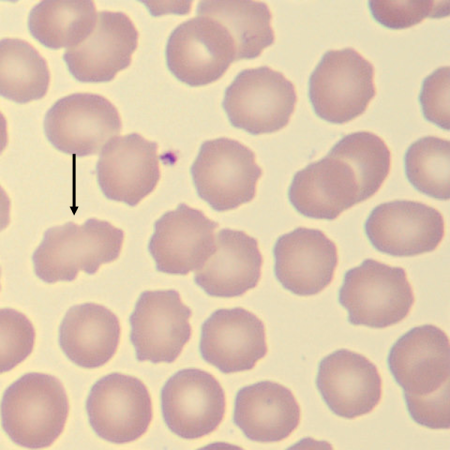
<p>What is the shape of this erythrocyte?</p>
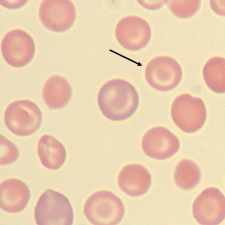
<p>What is the shape of this erythrocyte?</p>
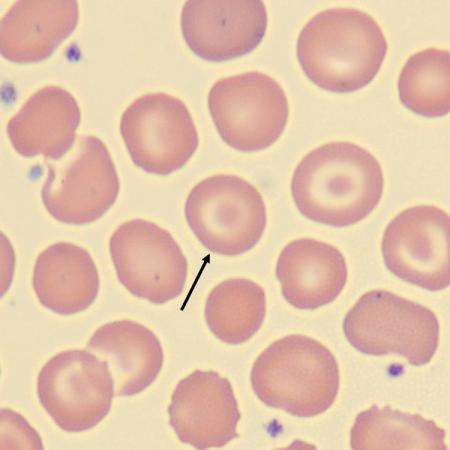
<p>What is the shape of this erythrocyte?</p>
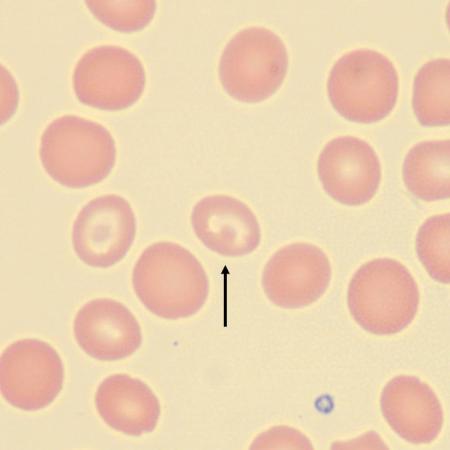
<p>What is the shape of this erythrocyte?</p>
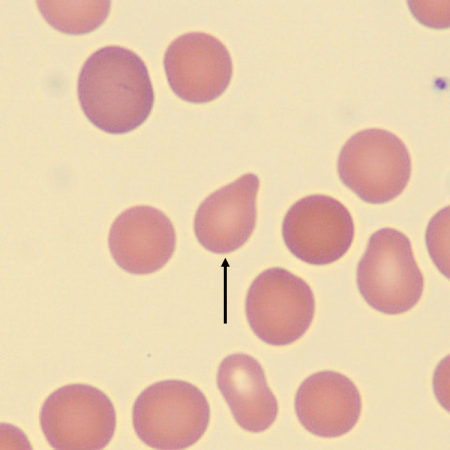
<p>What is the shape of this erythrocyte?</p>
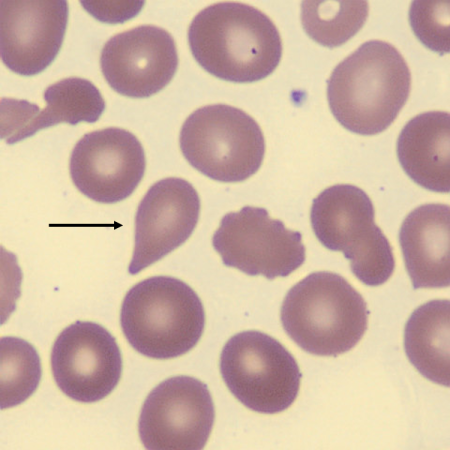
<p>What is the shape of this erythrocyte?</p>
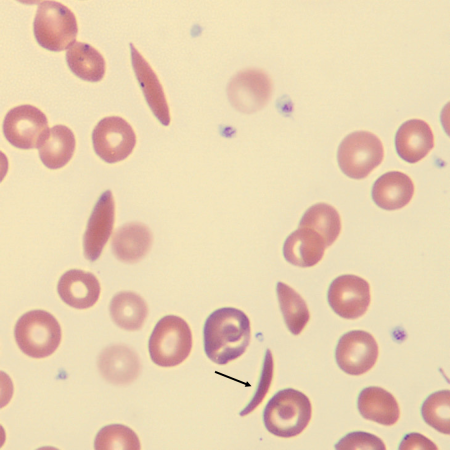
<p>What is the shape of this erythrocyte?</p>
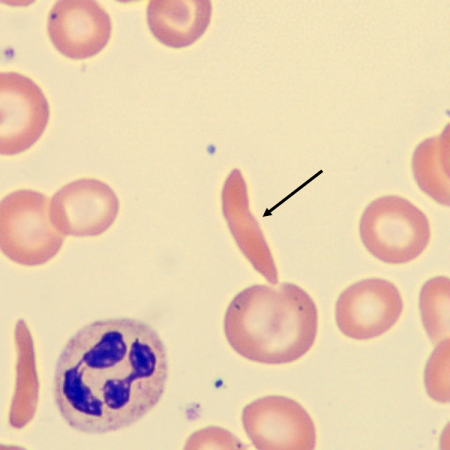
<p>What is the shape of this erythrocyte?</p>
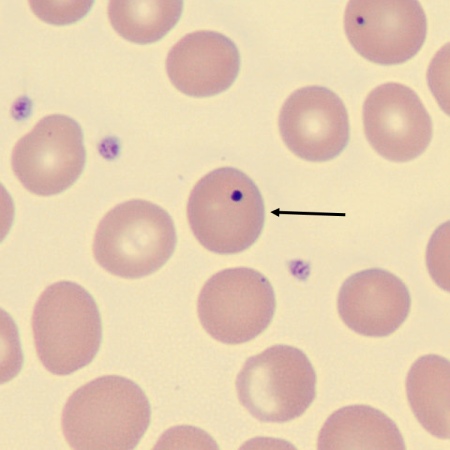
<p>What is the inclusion in this erythrocyte?</p>
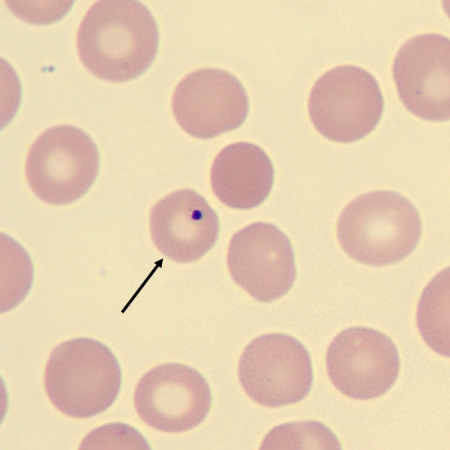
<p>What is the inclusion in this erythrocyte?</p>
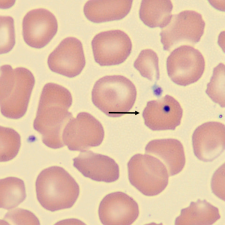
<p>What is the inclusion in this erythrocyte?</p>
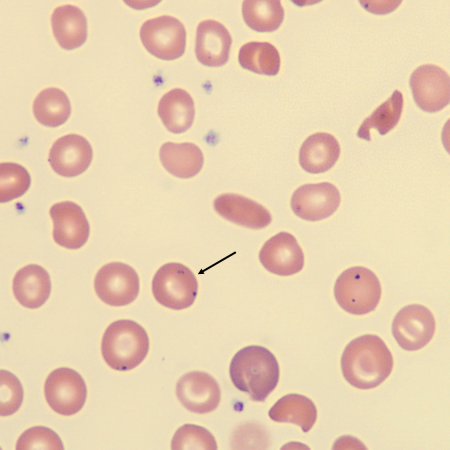
<p>What is the inclusion in this erythrocyte?</p>
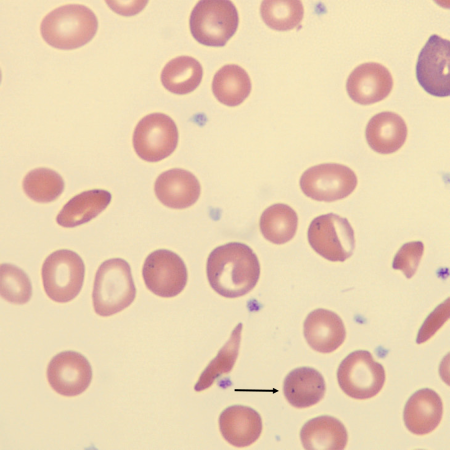
<p>What is the inclusion in this erythrocyte?</p>
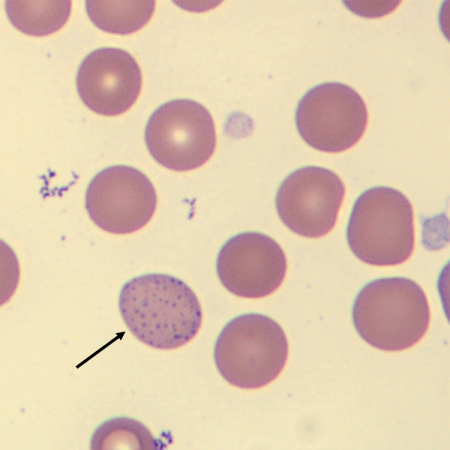
<p>What is the inclusion in this erythrocyte?</p>
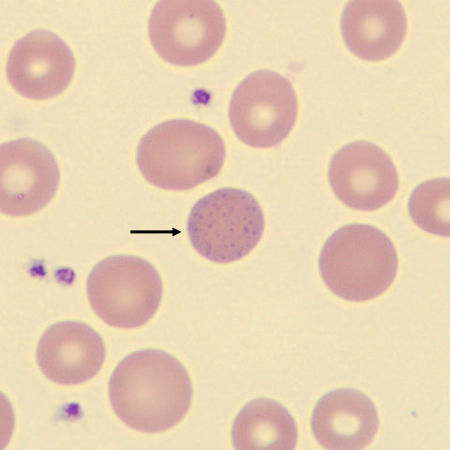
<p>What is the inclusion in this erythrocyte?</p>
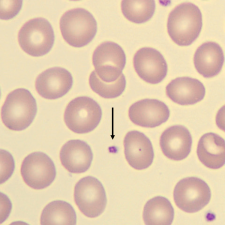
<p>What is this?</p>
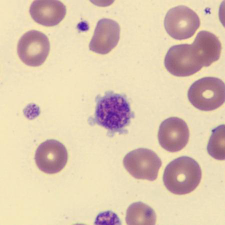
<p>What is this?</p>
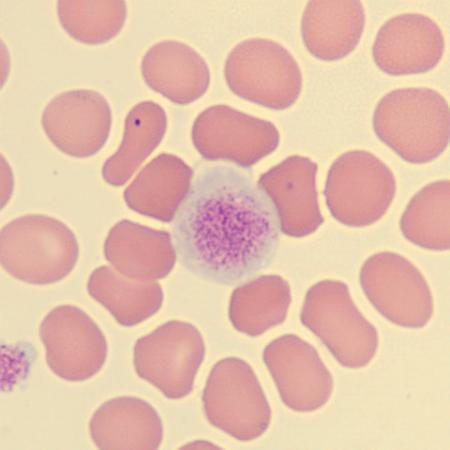
<p>What is this?</p>
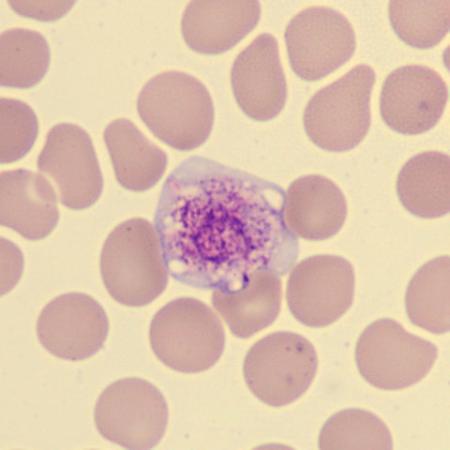
<p>What is this?</p>
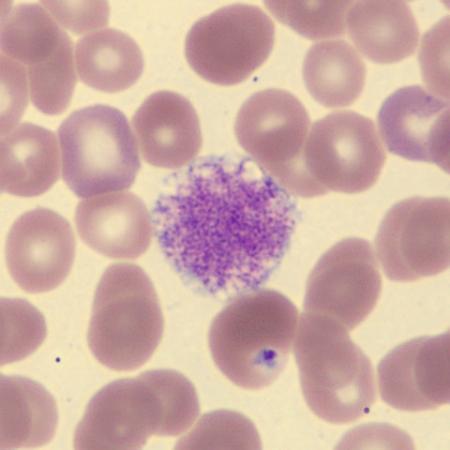
<p>What is this?</p>
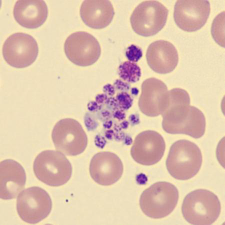
<p>What is this?</p>
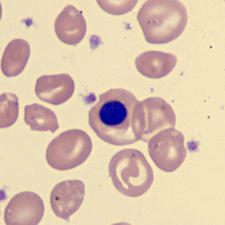
<p>What is this erythrocyte?</p>
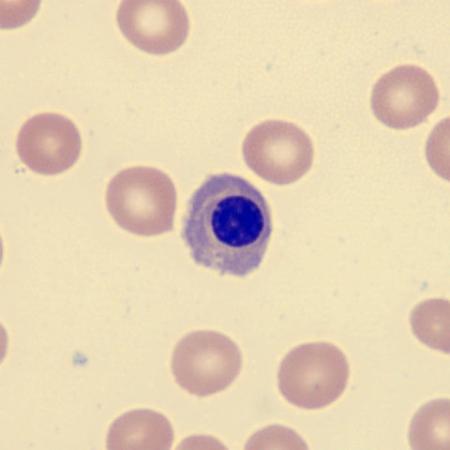
<p>What is this erythrocyte?</p>
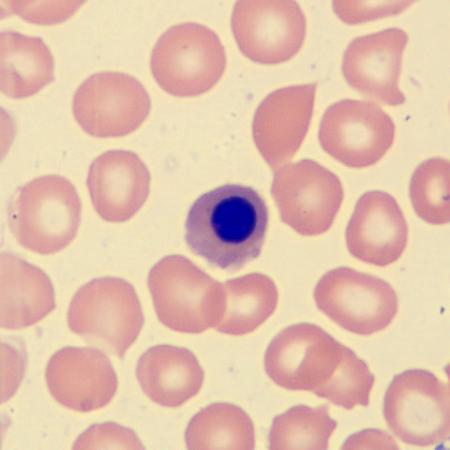
<p>What is this erythrocyte?</p>

1/64
For those who need/want extra practice identifying erythrocytes.
Name | Mastery | Learn | Test | Matching | Spaced |
|---|
No study sessions yet.
What is the color of this erythrocyte?
POLYCHROMATIC
Polychromatic cells are larger in size than normal, mature erythrocytes.
Polychromatic erythrocytes are pinkish blue-grey in appearance due to residual ribosomal DNA.
Polychromatic cells are released prematurely from the bone marrow because of intense stimulation of erythropoietin, particularly in response to hemolytic anemia.

What is the color of this erythrocyte?
POLYCHROMATIC #2
Polychromatic cells are larger in size than normal, mature erythrocytes.
Polychromatic erythrocytes are pinkish blue-grey in appearance due to residual ribosomal DNA.
Polychromatic cells are released prematurely from the bone marrow because of intense stimulation of erythropoietin, particularly in response to hemolytic anemia.

What characteristic describes this erythrocyte?
HYPOCHROMASIA
Hypochromatic erythrocytes have a low concentration of hemoglobin which results in a central pallor more than one third of the cell diameter.
Hypochromatic erythrocytes can be seen in different types of anemias.

What characteristic describes this erythrocyte?
HYPOCHROMSIA #2
Hypochromatic erythrocytes have a low concentration of hemoglobin which results in a central pallor more than one third of the cell diameter.
Hypochromatic erythrocytes can be seen in different types of anemias.
What characteristic describes this erythrocyte?
HYPERCHROMASIA
Hyperchromatic erythrocytes are deeply stained erythrocytes, lacking inner pallor.
Hyperchromasia can be seen when the MCHC is increased.
What characteristic describes this erythrocyte?
HYPERCHROMASIA #2
Hyperchromatic erythrocytes are deeply stained erythrocytes, lacking inner pallor.
Hyperchromasia can be seen when the MCHC is increased.
What characteristic describes the size of this erythrocyte?
NORMOCYTIC
Normal erythrocytes have a diameter of 7–8 μm.
Normal erythrocytes normally show very little variation in size.
What characteristic describes the size of this erythrocyte?
NORMOCYTIC #2
Normal erythrocytes have a diameter of 7–8 μm.
Normal erythrocytes normally show very little variation in size.
What do these erythrocytes show?
ANISOCYTOSIS
Anisocytosis is an increased variability in RBC size.
Anisocytosis is nonspecific and will be reflected in an increased red cell distribution width (RDW) in automated analyzer counts.
Anisocytosis can be seen in megaloblastic anemias.
What do these erythrocytes show?
ANISOCYTOSIS #2
Anisocytosis is an increased variability in RBC size.
Anisocytosis is nonspecific and will be reflected in an increased red cell distribution width (RDW) in automated analyzer counts.
Anisocytosis can be seen in megaloblastic anemias.
What do these erythrocytes show?
ANISOCYTOSIS #3
Anisocytosis is an increased variability in RBC size.
Anisocytosis is nonspecific and will be reflected in an increased red cell distribution width (RDW) in automated analyzer counts.
Anisocytosis can be seen in megaloblastic anemias.

What characteristic describes the size of this erythrocyte?
MICROCYTIC
Microcytes have a diameter less than 6.5 µm (MCV < 80 fL).
The red cells of healthy children are physiologically smaller than in adults, so it is important that red cell size be interpreted in the context of the age of the patient.
What characteristic describes the size of this erythrocyte?
MICROCYTIC #2
Microcytes have a diameter less than 6.5 µm (MCV < 80 fL).
The red cells of healthy children are physiologically smaller than in adults, so it is important that red cell size be interpreted in the context of the age of the patient.
What characteristic describes the size of this erythrocyte?
MACROCYTIC
Macrocytes have a diameter greater than 8.5 µm (MCV > 100 fL).
Macrocytes may be round or oval in shape, which can have diagnostic significance.
Macrocytes can be seen in megaloblastic anemias and B12 deficiency.
What characteristic describes the size of this erythrocyte?
MACROCYTIC #2
Macrocytes have a diameter greater than 8.5 µm (MCV > 100 fL).
Macrocytes may be round or oval in shape, which can have diagnostic significance.
Macrocytes can be seen in megaloblastic anemias and B12 deficiency.
What do these erythrocytes show?
POIKILOCYTOSIS
Poikilocytosis is an indication of a large variation in shape of the erythrocytes.
What do these erythrocytes show?
POIKILOCYTOSIS #2
Poikilocytosis is an indication of a large variation in shape of the erythrocytes.

What do these erythrocytes show?
POIKILOCYTOSIS #3
Poikilocytosis is an indication of a large variation in shape of the erythrocytes.
What is the shape of this erythrocyte?
SPHEROCYTE
Spherocytes are small in diameter (<6.5 µm).
Spherocytes are dense, spheroidal RBCs with a normal or decreased MCV and an absence of central pallor.
Spherocytes may be formed as a consequence of an abnormality of the RBC cytoskeleton and membrane
or from immune and microangiopathic hemolysis or as direct damage to the red cell membrane.
What is the shape of this erythrocyte?
SPHEROCYTE #2
Spherocytes are small in diameter (<6.5 µm).
Spherocytes are dense, spheroidal RBCs with a normal or decreased MCV and an absence of central pallor.
Spherocytes may be formed as a consequence of an abnormality of the RBC cytoskeleton and membrane
or from immune and microangiopathic hemolysis or as direct damage to the red cell membrane.

What is the shape of this erythrocyte?
ELLIPTOCYTE
Elliptocytes are cells with an elliptical shape (the long axis is more than twice the short axis).
Elliptocytes are normocytic and normochromic.
Elliptocytes can be seen in hereditary elliptocytosis.
What is the shape of this erythrocyte?
ELLIPTOCYTE #2
Elliptocytes are cells with an elliptical shape (the long axis is more than twice the short axis).
Elliptocytes are normocytic and normochromic.
Elliptocytes can be seen in hereditary elliptocytosis.
What is the shape of this erythrocyte?
OVALOCYTE
Ovalocytes have an oval shape (the long axis is less than twice the short axis).
Ovalocytes can be seen in a hereditary condition or an iron deficiency anemia.
Macro-ovalocytes are typical of megaloblastic erythropoiesis.

What is the shape of this erythrocyte?
OVALOCYTE #2
Ovalocytes have an oval shape (the long axis is less than twice the short axis).
Ovalocytes can be seen in a hereditary condition or an iron deficiency anemia.
Macro-ovalocytes are typical of megaloblastic erythropoiesis.
What is the shape of this erythrocyte?
STOMATOCYTE
Stomatocytes are uniconcave cup-shaped red blood cells that appear with a slit-like area of central pallor.
Stomatocytes are common artefacts in blood films.
The presence of stomatocytes reflects a hyperhydration of the cell and can be seen in increased numbers in various conditions such as hepatic abnormalities and acute alcoholic intoxication.

What is the shape of this erythrocyte?
STOMATOCYTE #2
Stomatocytes are uniconcave cup-shaped red blood cells that appear with a slit-like area of central pallor.
Stomatocytes are common artefacts in blood films.
The presence of stomatocytes reflects a hyperhydration of the cell and can be seen in increased numbers in various conditions such as hepatic abnormalities and acute alcoholic intoxication.
What is the shape of this erythrocyte?
SCHISTOCYTE
Schistocytes are fragments of red blood cells that are produced by extrinsic mechanical damage within the circulation.
Schistocytes are always smaller than intact red cells and can have the shape of fragments with sharp angles and straight borders, small crescents, helmet cells, or keratocytes.
Schistocytes are a diagnostic feature of Microangiopathic Hemolytic Anemia (MAHA).
What is the shape of this erythrocyte?
SCHISTOCYTE #2
Schistocytes are fragments of red blood cells that are produced by extrinsic mechanical damage within the circulation.
Schistocytes are always smaller than intact red cells and can have the shape of fragments with sharp angles and straight borders, small crescents, helmet cells, or keratocytes.
Schistocytes are a diagnostic feature of Microangiopathic Hemolytic Anemia (MAHA).
What is the shape of this erythrocyte?
HELMET CELL
• Helmet cells are a specific morphological subtype of schistocyte, recognized by their sharp, “helmet-shaped” appearance caused by mechanical RBC fragmentation.
• Helmet cells can be seen in thalassemia, as well as other conditions involving RBC damage or membrane loss.

What is the shape of this erythrocyte?
HELMET CELL #2
• Helmet cells are a specific morphological subtype of schistocyte, recognized by their sharp, “helmet-shaped” appearance caused by mechanical RBC fragmentation.
• Helmet cells can be seen in thalassemia, as well as other conditions involving RBC damage or membrane loss.
What is the shape of this erythrocyte?
ACANTHOCYTE
Acanthocytes are round, hyperchromic red cells with 2–20 irregularly spaced projections or spicules of variable length, thickness, and shape.
Acanthocytes can be seen in, for example, abetalipoproteinemia and hepatic cirrhosis due to alcohol.

What is the shape of this erythrocyte?
ACANTHOCYTE #2
Acanthocytes are round, hyperchromic red cells with 2–20 irregularly spaced projections or spicules of variable length, thickness, and shape.
Acanthocytes can be seen in, for example, abetalipoproteinemia and hepatic cirrhosis due to alcohol.

What is the shape of this erythrocyte?
ACANTHOCYTE #3
Acanthocytes are round, hyperchromic red cells with 2–20 irregularly spaced projections or spicules of variable length, thickness, and shape.
Acanthocytes can be seen in, for example, abetalipoproteinemia and hepatic cirrhosis due to alcohol.

What is the shape of this erythrocyte?
BURR CELL
Burr cells are red cells that have lost their disc shape and are covered with 10–30 short blunt projections or spicules of fairly regular form.
Burr cells can be seen, for example, in patients with uremia and in inherited non-spherocytic hemolytic anemia due to pyruvate kinase deficiency.
Burr cells are often a technical artefact on the blood smear due to old sample and poor drying.
What is the shape of this erythrocyte?
BURR CELL #2
Burr cells are red cells that have lost their disc shape and are covered with 10–30 short blunt projections or spicules of fairly regular form.
Burr cells can be seen, for example, in patients with uremia and in inherited non-spherocytic hemolytic anemia due to pyruvate kinase deficiency.
Burr cells are often a technical artefact on the blood smear due to old sample and poor drying.
What is the shape of this erythrocyte?
BURR CELL #3
Burr cells are red cells that have lost their disc shape and are covered with 10–30 short blunt projections or spicules of fairly regular form.
Burr cells can be seen, for example, in patients with uremia and in inherited non-spherocytic hemolytic anemia due to pyruvate kinase deficiency.
Burr cells are often a technical artefact on the blood smear due to old sample and poor drying.
What is the shape of this erythrocyte?
TARGET CELL
Target cells are an anomaly of intracellular distribution of hemoglobin that leads to the dark central hemoglobinized area in the middle of the cell, surrounded by a hypochromic ring that is surrounded in turn by a second dark peripheral ring (“bull’s-eye”).
Target cells are seen in: thalassemia, hemoglobin C disease, obstructive jaundice, and hyposplenism.
What is the shape of this erythrocyte?
TARGET CELL #2
Target cells are an anomaly of intracellular distribution of hemoglobin that leads to the dark central hemoglobinized area in the middle of the cell, surrounded by a hypochromic ring that is surrounded in turn by a second dark peripheral ring (“bull’s-eye”).
Target cells are seen in: thalassemia, hemoglobin C disease, obstructive jaundice, and hyposplenism.
What is the shape of this erythrocyte?
TARGET CELL #3
Target cells are an anomaly of intracellular distribution of hemoglobin that leads to the dark central hemoglobinized area in the middle of the cell, surrounded by a hypochromic ring that is surrounded in turn by a second dark peripheral ring (“bull’s-eye”).
Target cells are seen in: thalassemia, hemoglobin C disease, obstructive jaundice, and hyposplenism.

What is the shape of this erythrocyte?
TEAR DROP CELL
Teardrop cells are red cells that are pear or teardrop in shape.
Teardrop cells can be seen in, for example, megaloblastic anemias and/or thalassemia.
What is the shape of this erythrocyte?
TEAR DROP CELL #2
Teardrop cells are red cells that are pear or teardrop in shape.
Teardrop cells can be seen in, for example, megaloblastic anemias and/or thalassemia.
What is the shape of this erythrocyte?
TEAR DROP CELL #3
Teardrop cells are red cells that are pear or teardrop in shape.
Teardrop cells can be seen in, for example, megaloblastic anemias and/or thalassemia.
What is the shape of this erythrocyte?
SICKLE CELL
Sickle cells are red cells that become crescent or sickle-shaped with pointed ends as a result of polymerization of HbS.
Sickle cells are present in sickle cell anemia.
What is the shape of this erythrocyte?
SICKLE CELL #2
Sickle cells are red cells that become crescent or sickle-shaped with pointed ends as a result of polymerization of HbS.
Sickle cells are present in sickle cell anemia.
What is the inclusion in this erythrocyte?
HOWELL-JOLLY BODIES
Howell–Jolly bodies are usually single, small (1 µm), dense, perfectly round basophilic inclusions that are fragments of nuclear material (DNA).
Howell–Jolly bodies can be seen in hemolytic anemias and in splenectomies.
What is the inclusion in this erythrocyte?
HOWELL-JOLLY BODIES #2
Howell–Jolly bodies are usually single, small (1 µm), dense, perfectly round basophilic inclusions that are fragments of nuclear material (DNA).
Howell–Jolly bodies can be seen in hemolytic anemias and in splenectomies.
What is the inclusion in this erythrocyte?
HOWELL-JOLLY BODIES #3
Howell–Jolly bodies are usually single, small (1 µm), dense, perfectly round basophilic inclusions that are fragments of nuclear material (DNA).
Howell–Jolly bodies can be seen in hemolytic anemias and in splenectomies.
What is the inclusion in this erythrocyte?
PAPPENHEIMER BODIES
Pappenheimer bodies are ferritin aggregates in red cells, visible in Romanowsky-stained PB films as multiple basophilic inclusions of variable size, shape, and distribution, usually in a limited cytoplasmic area.
Pappenheimer bodies can be seen in sideroblastic anemias and in splenectomies.
What is the inclusion in this erythrocyte?
PAPPENHEIMER BODIES #2
Pappenheimer bodies are ferritin aggregates in red cells, visible in Romanowsky-stained PB films as multiple basophilic inclusions of variable size, shape, and distribution, usually in a limited cytoplasmic area.
Pappenheimer bodies can be seen in sideroblastic anemias and in splenectomies.

What is the inclusion in this erythrocyte?
PAPPENHEIMER BODIES #3
Pappenheimer bodies are ferritin aggregates in red cells, visible in Romanowsky-stained PB films as multiple basophilic inclusions of variable size, shape, and distribution, usually in a limited cytoplasmic area.
Pappenheimer bodies can be seen in sideroblastic anemias and in splenectomies.
What is the inclusion in this erythrocyte?
BASOPHILIC STIPPLING
Basophilic stippling describes the occurrence of fine, medium, or coarse blue granules due to abnormally aggregated ribosomes, uniformly distributed throughout the RBC.
Basophilic stippling can be seen in cases of lead poisoning or in a variety of diseases often associated with an anemia.
What is the inclusion in this erythrocyte?
BASOPHILIC STIPPLING #2
Basophilic stippling describes the occurrence of fine, medium, or coarse blue granules due to abnormally aggregated ribosomes, uniformly distributed throughout the RBC.
Basophilic stippling can be seen in cases of lead poisoning or in a variety of diseases often associated with an anemia.

What is the inclusion in this erythrocyte?
BASOPHILIC STIPPLING #3
Basophilic stippling describes the occurrence of fine, medium, or coarse blue granules due to abnormally aggregated ribosomes, uniformly distributed throughout the RBC.
Basophilic stippling can be seen in cases of lead poisoning or in a variety of diseases often associated with an anemia.
What is this?
PLATELETS / THROMBOCYTES
A normal thrombocyte measures 1.5–3 µm in diameter.
Thrombocytes are fractions of the cytoplasm of the megakaryocytes.
Thrombocytes play a big role in the body coagulation process.

What is this?
PLATELETS / THROMBOCYTES #2
A normal thrombocyte measures 1.5–3 µm in diameter.
Thrombocytes are fractions of the cytoplasm of the megakaryocytes.
Thrombocytes play a big role in the body coagulation process.

What is this?
LARGE PLATELET / THROMBOCYTE
Large thrombocytes measure 3–7 µm; roughly the diameter of a normal-sized red cell.
What is this?
LARGE PLATELET / THROMBOCYTE #2
Large thrombocytes measure 3–7 µm; roughly the diameter of a normal-sized red cell.
What is this?
GIANT PLATELET / THROMBOCYTE
Giant thrombocytes are larger than normal sized red cells at >7 µm in diameter.
Giant thrombocytes are associated with various thrombocytopenia and myeloproliferative disorders.
What is this?
GIANT PLATELET / THROMBOCYTE #2
Giant thrombocytes are larger than normal sized red cells at >7 µm in diameter.
Giant thrombocytes are associated with various thrombocytopenia and myeloproliferative disorders.
What is this?
GIANT PLATELET / THROMBOCYTE #3
Giant thrombocytes are larger than normal sized red cells at >7 µm in diameter.
Giant thrombocytes are associated with various thrombocytopenia and myeloproliferative disorders.
What is this?
PLATELET / THROMBOCYTE AGGREGATION
Thrombocyte aggregation is when three or more thrombocytes are clumped together.
Thrombocyte aggregation can be seen in patients with an ongoing coagulation process in vivo, or it can be an in vitro artifact due to the EDTA anticoagulant in the sample tube.

What is this?
PLATELET / THROMBOCYTE AGGREGATION #2
Thrombocyte aggregation is when three or more thrombocytes are clumped together.
Thrombocyte aggregation can be seen in patients with an ongoing coagulation process in vivo, or it can be an in vitro artifact due to the EDTA anticoagulant in the sample tube.
What is this erythrocyte?
NRBC
• A nucleated red blood cell is a red cell precursor and is used to describe an erythroblast in the peripheral circulation.
• NRBCs are reported as an absolute count within the differential with the WBC corrected for the presence of NRBCs, or as number of NRBCs per 100 WBC.
What is this erythrocyte?
NRBC #2
• A nucleated red blood cell is a red cell precursor and is used to describe an erythroblast in the peripheral circulation.
• NRBCs are reported as an absolute count within the differential with the WBC corrected for the presence of NRBCs, or as number of NRBCs per 100 WBC.
What is this erythrocyte?
NRBC #3
• A nucleated red blood cell is a red cell precursor and is used to describe an erythroblast in the peripheral circulation.
• NRBCs are reported as an absolute count within the differential with the WBC corrected for the presence of NRBCs, or as number of NRBCs per 100 WBC.